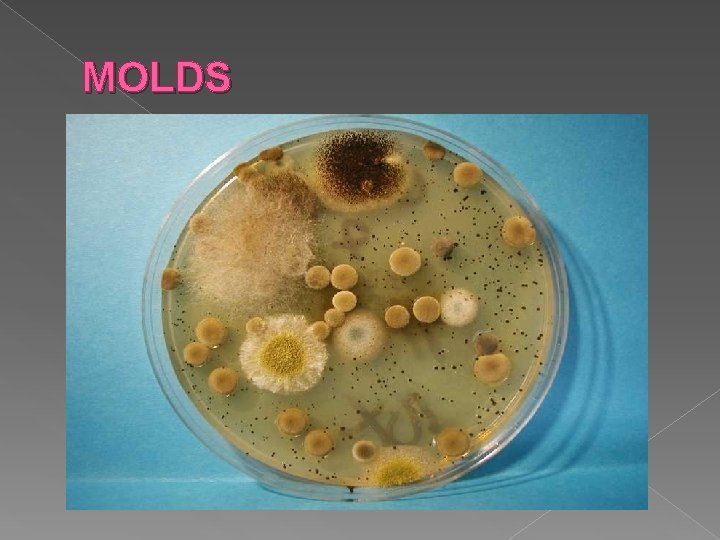
MOLDS

Classification Chapter 18 Honors Lab Biology TAXONOMY Is

Classification Chapter 18 Honors & Lab Biology

TAXONOMY Is the branch of biology that names and groups organisms according to their characteristics and evolutionary history. ARISTOTLE (Greek philosopher) – was the first to classify organisms more than 2, 000 year ago Classified by land, air, and water dwellers 15 th and 16 th centuries Aristotle’s system seemed adequate Then, scientist began to see a problem with “common names” ex: jellyfish not a fish robin, fir tree

LINNAEUS’S SYSTEM Carolus Linnaeus (1707 -1778) Swedish naturalist › Grouping organisms into hierarchical categories › First he used morphology (form & structure) › Then phylogeny (evolutionary history of organism)

Levels of Classification KINGDOM PHYLUM CLASS ORDER FAMILY GENUS SPECIES - king philip came over for good spaghetti

Binomial Nomenclature Genus species RULE: › Genus name is CAPITALIZED and both names are underlined or written in italics!!!! › Ex: Panthera leo, Panthera tigris, Felis domestica, Felis concolor

TWO Modern Systems of Classification Six Kingdom System › › › 1. Archaebacteria 2. Eubacteria 3. Protista 4. Fungi 5. Plantae 6. Animalia


Three Domain System

Kingdom Archaebacteria Archae = ancient unicellular Prokaryotes Autotrophic – chemosynthesis Waste methane Live in harsh environments such as sulfurous hot springs, salty lakes Also live in anaerobic environments such as intestines of mammals May be direct descendents of first organisms on Earth (before evolution of photosynthesis & O 2)

Archaebacteria black smoker: EXTREMOPHILES!!! the colonies thrive in complete darkness, without oxygen, surrounded by superheated water, and bathed in a chemical soup of hydrogen sulfide and other dissolved minerals. That's extreme!

Hot underwater volcanic vent! Found in hot springs in Yellowstone Park !

Kingdom Eubacteria Eu = “true” Unicellular prokaryotes Most of the bacteria that affect your life Cause: tooth decay, turn milk into yogurt, cause food poisoning Most USE OXYGEN Include the GREATEST NUMBER OF LIVING THINGS ON EARTH!! Reproduce by binary fission (30 min. ) WOW!

Most abundant yet you can’t see them with the naked eye!!!!!

This is the bacteria found in CHEESE!!!

Kingdom Protista Made up of variety of eukaryotic, mostly single celled organisms Some exist as multicellular organisms ex: “giant kelp” = looks like a plant BUT lacks specialized tissues This kingdom contains all eukaryotes that are NOT plants, animals or fungi More than 50, 000 species

Giant Kelp

Examples of Protists: Euglena and Ameoba (unicellular) Euglena = can feed on other organisms like animals BUT also have chloroplast and can go through photosynthesis

Amoeba Feed on other organisms and respond to touch and light.

Kingdom Fungi Heterotrophic unicellular & multicellular eukaryotic organisms ABSORB nutrients Over 100, 000 species including mushrooms, puffballs, rusts, smuts, mildews, and molds!

Puffballs found in Wisconsin

Soybean Rust Pustules
MOLDS

Smut Fungus on Corn

Athletes Foot Fungus

Kingdom Plantae Multicellular plants Autotrophic and use photosynthesis 350, 000 species include: mosses, ferns, conifers, & flowering plants


Kingdom Animalia Eukaryotic, multicellular heterotrophic organisms Most have symmetrical body organization

- Slides: 28